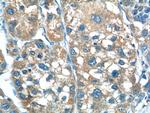
TP53INP1 Antibody in Immunohistochemistry (Paraffin) (IHC (P))
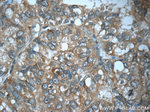
TP53INP1 Antibody in Immunohistochemistry (Paraffin) (IHC (P))
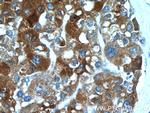
TP53INP1 Antibody in Immunohistochemistry (Paraffin) (IHC (P))

Search
Proteintech
TP53INP1 Polyclonal Antibody
{{$productOrderCtrl.translations['antibody.pdp.commerceCard.promotion.promotions']}}
{{$productOrderCtrl.translations['antibody.pdp.commerceCard.promotion.viewpromo']}}
{{$productOrderCtrl.translations['antibody.pdp.commerceCard.promotion.promocode']}}: {{promo.promoCode}} {{promo.promoTitle}} {{promo.promoDescription}}. {{$productOrderCtrl.translations['antibody.pdp.commerceCard.promotion.learnmore']}}
产品信息
17872-1-AP
种属反应
已发表种属
宿主/亚型
分类
类型
抗原
偶联物
形式
浓度
规格
纯化类型
保存液
内含物
保存条件
运输条件
产品详细信息
Immunogen sequence: MFQRLNKMF VGEVSSSSNQ EPEFNEKEDD EWILVDFIDT CTGFSAEEEE EEEDISEESP TEHPSVFSCL PASLECLADT SDSCFLQFES CPMEESWFIT PPPCFTAGGL TTIKVETSPM ENLLIEHPSM SVYAVHNSCP GLSEATRGTD ELHSPSSPRV EAQNEMGQHI HCYVAALAAH TTFLEQPKSF RPSQWIKEHS ERQPLNRNSL RRQNLTRDCH PRQVKHNGWV VHQPCPRQYN Y (1-240 aa encoded by BC074868)
靶标信息
A novel p53 inducible gene was identified and designated p53DINP1 (for p53-dependent damage-inducible nuclear protein). p53DINP1 may regulate p53-dependent apoptosis through phosphorylation at Ser46 and induction of p53AIP1. p53DINP1/SIP is expressed in many tissues and induced by a variety of stress agents including UV stress, mutagenic stress, heat shock, and oxidative stress.
仅用于科研。不用于诊断过程。未经明确授权不得转售。
生物信息学
蛋白别名: p53-dependent damage-inducible nuclear protein 1; p53-inducible p53DINP1; p53DINP1; stress induced protein; Stress-induced protein; TEAP; thymus expressed acidic protein; Thymus-expressed acidic protein; transformation related protein 53 inducible nuclear protein 1; Tumor protein p53-inducible nuclear protein 1; unnamed protein product
基因别名: 2700057G22Rik; P53DINP1; SIP; SIP18; SIP27; Stinp; Teap; TP53DINP1; TP53INP1; TP53INP1A; TP53INP1B; Trp53inp1
UniProt ID: (Human) Q96A56, (Rat) Q80YE2, (Mouse) Q9QXE4
Entrez Gene ID: (Human) 94241, (Rat) 297822, (Mouse) 60599